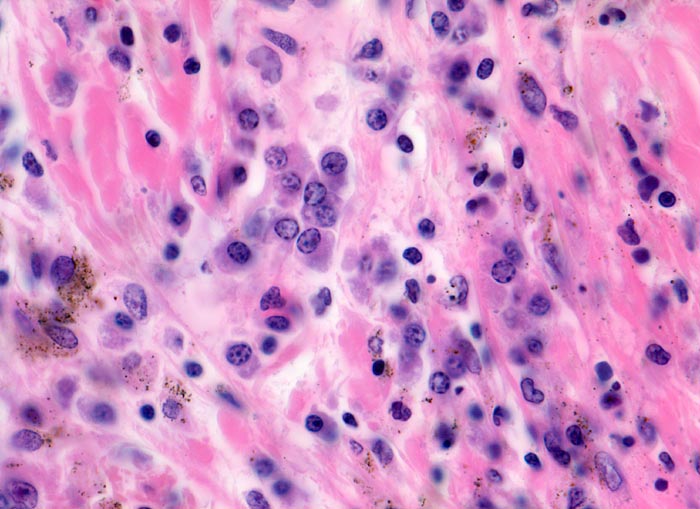
Pathorama

Systeloglossum es un género de orquídeas perteneciente a la subfamilia Epidendroideae dentro de la familia Orchidaceae. Tiene cinco especies.
Especies
Enlaces externos
- Wikimedia Commons alberga una categoría multimedia sobre Systeloglossum.
- Wikispecies tiene un artículo sobre Systeloglossum.
- Plant systematics
- PPP-index
- The International Plant Names Index
- Catalogue of Life
- Encyclopedia of Life
- http://orchids.wikia.com/wiki/Systeloglossum (enlace roto disponible en Internet Archive; véase el historial, la primera versión y la última).


![Lysosom • Entstehung, Aufbau und Funktion · [mit Video]](https://d1g9li960vagp7.cloudfront.net/wp-content/uploads/2023/02/Folie10-1-1024x576.jpg)